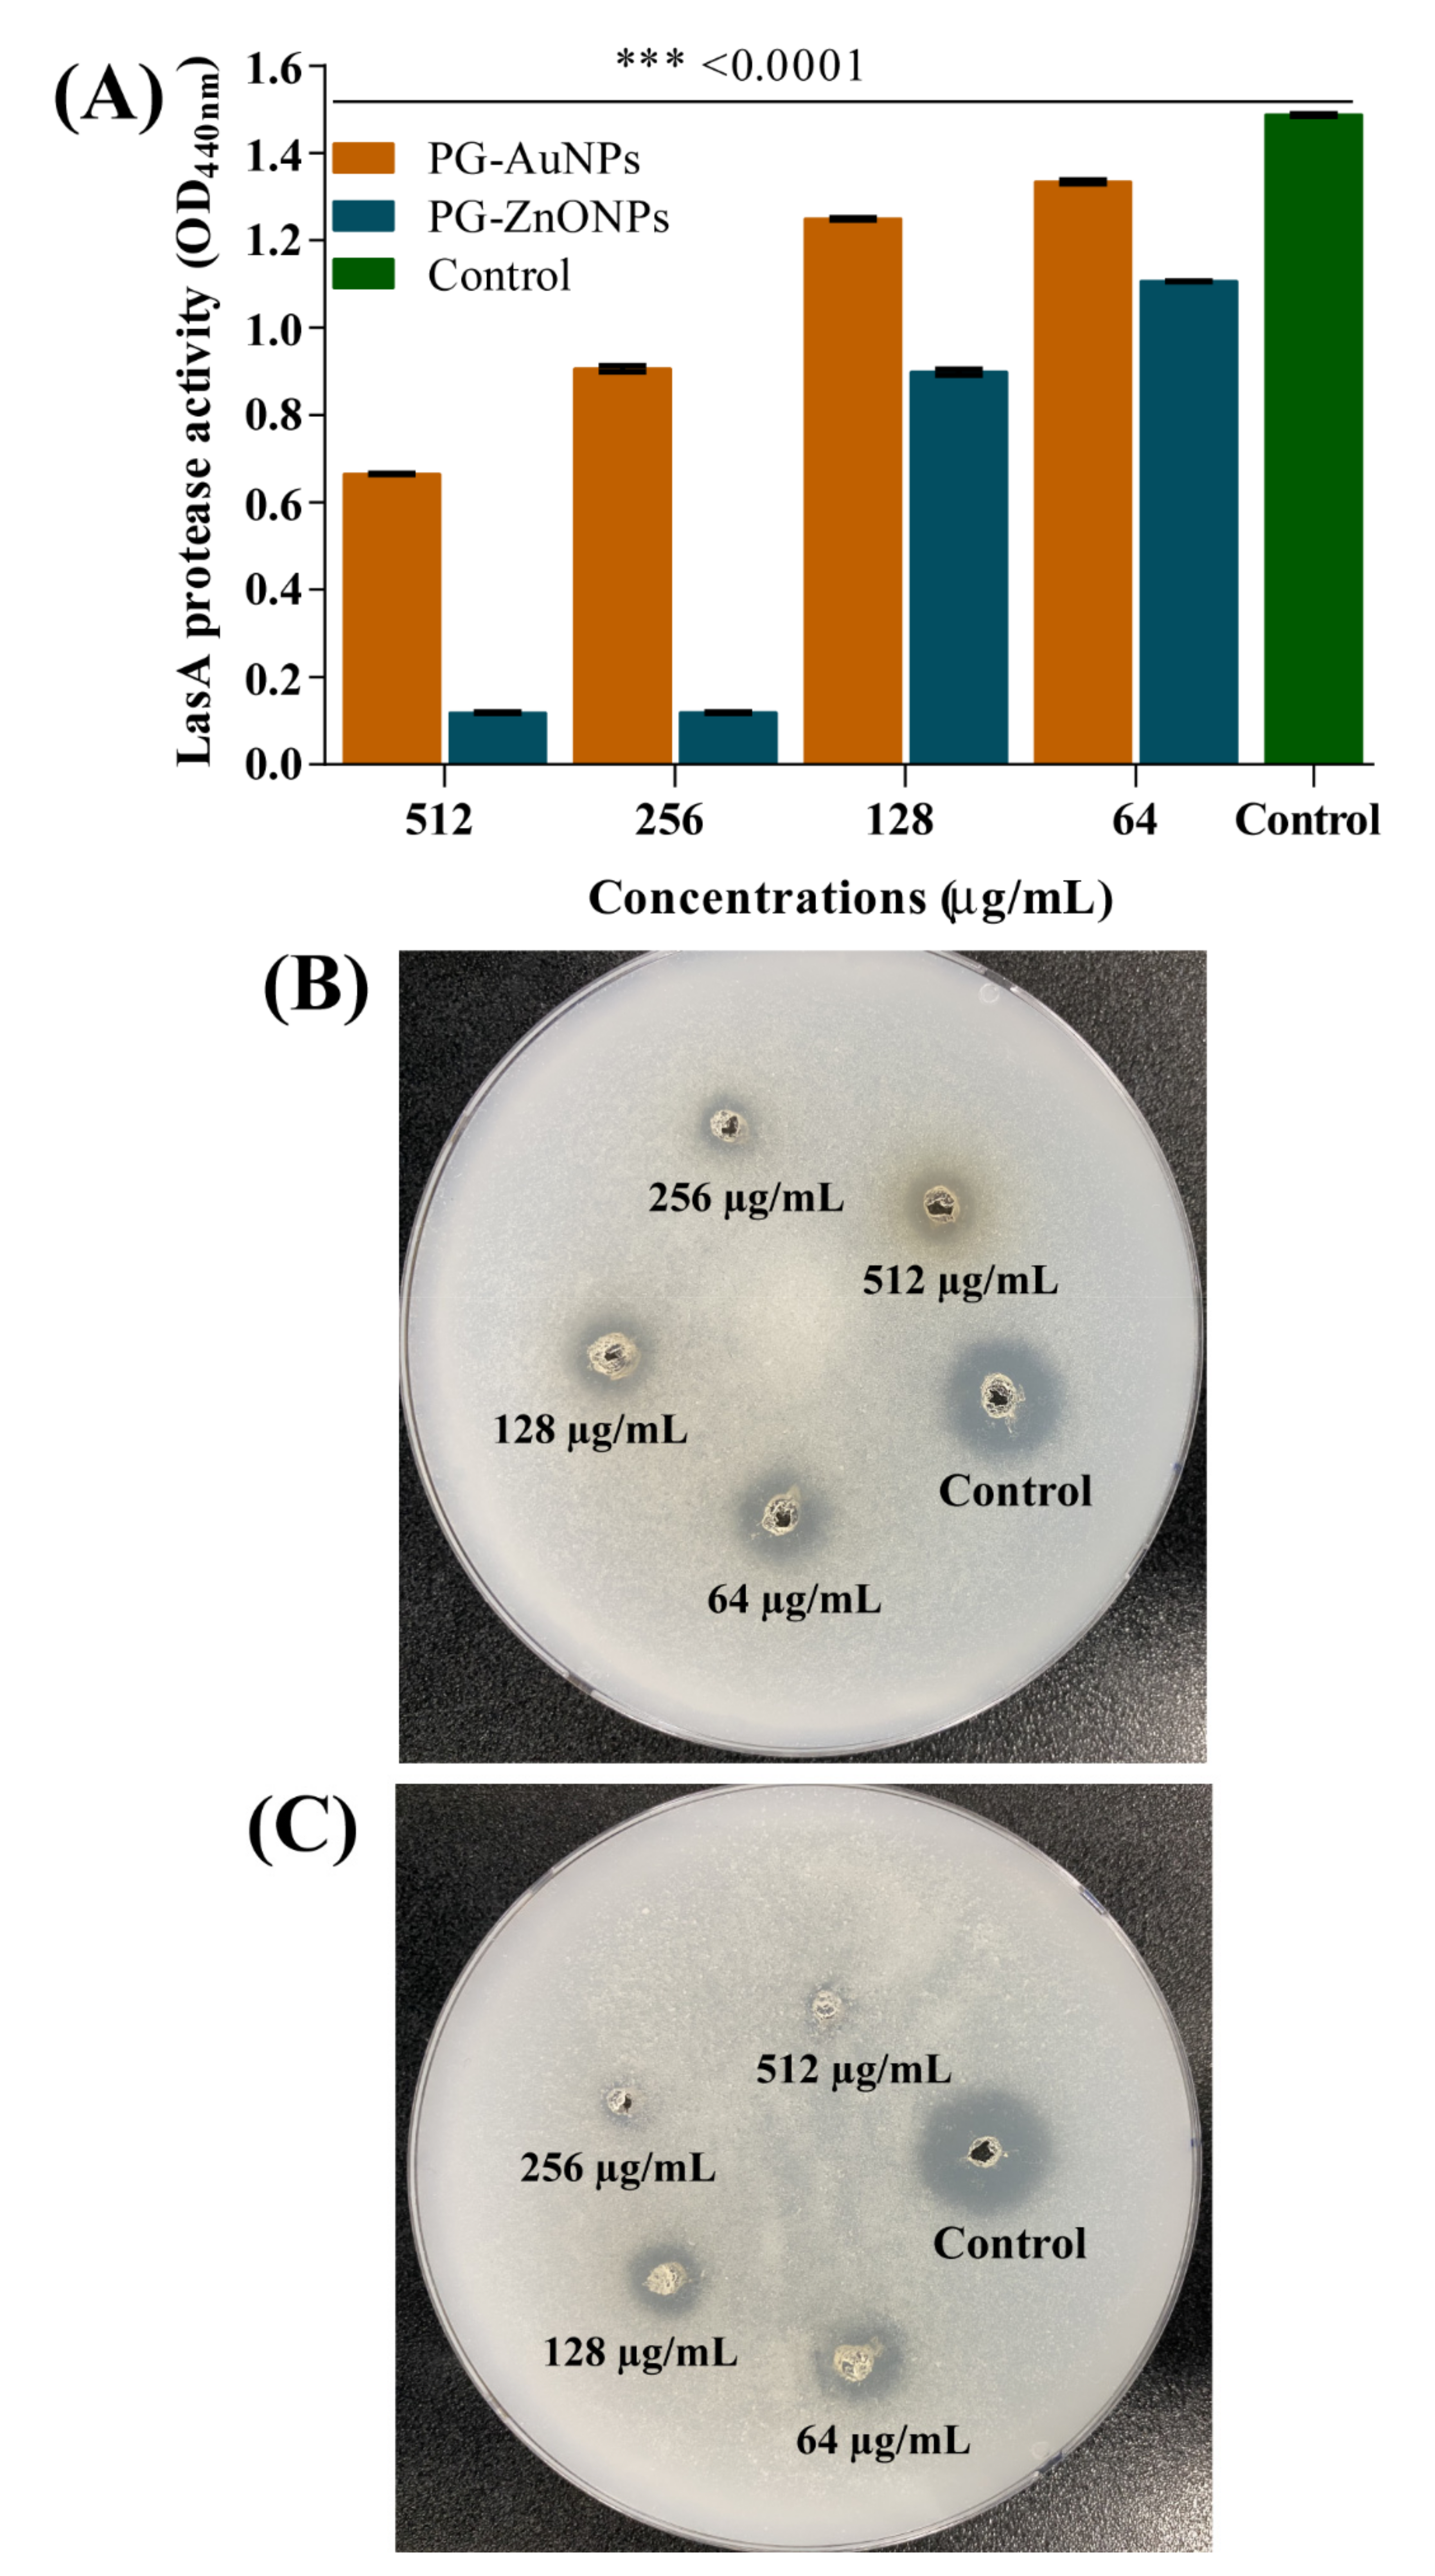
Marinedrugs 19 00601 g011 550

Phloroglucinol-Gold and -Zinc Oxide Nanoparticles: Antibiofilm and Antivirulence Activities towards Pseudomonas aeruginosa PAO1
Abstract
:1. Introduction
2. Results
2.1. Synthesis and Characterization of PG-AuNPs and PG-ZnONPs
2.2. Effect of PG, PG-AuNPs, PG-ZnONPs, and C-ZnONPs on the Growth Properties of P. aeruginosa
2.3. PG-AuNPs and PG-ZnONPs Inhibited Biofilm Formation and Eradicated Mature Biofilms
2.4. Inhibitory Effect of PG-AuNPs and PG-ZnONPs on Virulence Properties
2.5. In Vitro Cytotoxicity Assay
3. Discussion
4. Materials and Methods
4.1. Bacterial Strains, Culture Media, and Chemicals
4.2. Synthesis of Phloroglucinol Gold and Zinc Oxide Nanoparticles
4.3. Instrumental Characterization of PG-AuNPs and PG-ZnONPs
4.4. Minimum Inhibitory Concentration (MIC) of PG-AuNPs and PG-ZnONPs
4.5. Bacterial Biofilm Inhibition and Eradication Assays
4.6. Examination of Biofilm Architecture Using a Scanning Electron Microscope and Fluorescence Microscope
4.7. Assays for the Virulence Properties
4.8. In Vitro Cytotoxicity Assay
4.9. Statistical Analysis
5. Conclusions
Author Contributions
Funding
Institutional Review Board Statement
Conflicts of Interest
References
- Tredget, E.E.; Shankowsky, H.A.; Rennie, R.; Burrell, R.E.; Logsetty, S. Pseudomonas infections in the thermally injured patient. Burns 2004, 30, 3–26. [Google Scholar] [CrossRef]
- Sadikot, R.T.; Blackwell, T.S.; Christman, J.W.; Prince, A.S. Pathogen-host interactions in Pseudomonas aeruginosa pneumonia. Am. J. Respir. Crit. Care Med. 2005, 171, 1209–1223. [Google Scholar] [CrossRef] [Green Version]
- Rahme, L.G.; Ausubel, F.M.; Cao, H.; Drenkard, E.; Goumnerov, B.C.; Lau, G.W.; Mahajan-Miklos, S.; Plotnikova, J.; Tan, M.-W.; Tsongalis, J.; et al. Plants and animals share functionally common bacterial virulence factors. Proc. Natl. Acad. Sci. USA 2000, 97, 8815–8821. [Google Scholar] [CrossRef] [Green Version]
- Gellatly, S.L.; Hancock, R.E.W. Pseudomonas aeruginosa: New insights into pathogenesis and host defenses. Pathog. Dis. 2013, 67, 159–173. [Google Scholar] [CrossRef] [PubMed] [Green Version]
- Pang, Z.; Raudonis, R.; Glick, B.R.; Lin, T.-J.; Cheng, Z. Antibiotic resistance in Pseudomonas aeruginosa: Mechanisms and alternative therapeutic strategies. Biotechnol. Adv. 2019, 37, 177–192. [Google Scholar] [CrossRef]
- Ciofu, O.; Tolker-Nielsen, T. Tolerance and Resistance of Pseudomonas aeruginosa Biofilms to Antimicrobial Agents—How P. aeruginosa. Can. Escape Antibiotics. Front. Microbiol. 2019, 10, 913. [Google Scholar] [CrossRef] [Green Version]
- Thi, M.T.T.; Wibowo, D.; Rehm, B.H.A. Pseudomonas aeruginosa Biofilms. Int. J. Mol. Sci. 2020, 21, 8671. [Google Scholar] [CrossRef]
- Maurice, N.M.; Bedi, B.; Sadikot, R.T. Pseudomonas aeruginosa Biofilms: Host Response and Clinical Implications in Lung Infections. Am. J. Respir. Cell Mol. Biol. 2018, 58, 428–439. [Google Scholar] [CrossRef] [PubMed]
- Newman, J.W.; Floyd, R.V.; Fothergill, J.L. The contribution of Pseudomonas aeruginosa virulence factors and host factors in the establishment of urinary tract infections. FEMS Microbiol. Lett. 2017, 364, fnx124. [Google Scholar] [CrossRef] [PubMed]
- Khan, F.; Pham, D.T.N.; Oloketuyi, S.F.; Kim, Y.-M. Regulation and controlling the motility properties of Pseudomonas aeruginosa. Appl. Microbiol. Biotechnol. 2020, 104, 33–49. [Google Scholar] [CrossRef]
- Khan, F.; Pham, D.T.N.; Tabassum, N.; Oloketuyi, S.F.; Kim, Y.M. Treatment strategies targeting persister cell formation in bacterial pathogens. Crit. Rev. Microbiol. 2020, 46, 665–688. [Google Scholar] [CrossRef]
- Grosjean, M.; Guénard, S.; Giraud, C.; Muller, C.; Plésiat, P.; Juarez, P. Targeted Genome Reduction of Pseudomonas aeruginosa Strain PAO1 Led to the Development of Hypovirulent and Hypersusceptible rDNA Hosts. Front. Bioeng. Biotechnol. 2021, 9, 177. [Google Scholar] [CrossRef]
- Naseer, M.; Aslam, U.; Khalid, B.; Chen, B. Green route to synthesize Zinc Oxide Nanoparticles using leaf extracts of Cassia fistula and Melia azadarach and their antibacterial potential. Sci. Rep. 2020, 10, 9055. [Google Scholar] [CrossRef]
- Javaid, A.; Oloketuyi, S.F.; Khan, M.M.; Khan, F. Diversity of Bacterial Synthesis of Silver Nanoparticles. BioNanoScience 2018, 8, 43–59. [Google Scholar] [CrossRef]
- Guilger-Casagrande, M.; Lima, R.D. Synthesis of Silver Nanoparticles Mediated by Fungi: A Review. Front. Bioeng. Biotechnol. 2019, 7, 287. [Google Scholar] [CrossRef] [PubMed] [Green Version]
- Menon, S.; Rajeshkumar, S.; Kumar, V. A review on biogenic synthesis of gold nanoparticles, characterization, and its applications. Resour. Effic. Technol. 2017, 3, 516–527. [Google Scholar] [CrossRef]
- Naidi, S.N.; Harunsani, M.H.; Tan, A.L.; Khan, M.M. Green-synthesized CeO2 nanoparticles for photocatalytic, antimicrobial, antioxidant and cytotoxicity activities. J. Mater. Chem. B 2021, 9, 5599–5620. [Google Scholar] [CrossRef] [PubMed]
- Agarwal, H.; Venkat Kumar, S.; Rajeshkumar, S. A review on green synthesis of zinc oxide nanoparticles—An eco-friendly approach. Resour. Effic. Technol. 2017, 3, 406–413. [Google Scholar] [CrossRef]
- Iravani, S.; Varma, R.S. Sustainable synthesis of cobalt and cobalt oxide nanoparticles and their catalytic and biomedical applications. Green Chem. 2020, 22, 2643–2661. [Google Scholar] [CrossRef]
- Devatha, C.P.; Thalla, A.K. Chapter 7—Green Synthesis of Nanomaterials. In Synthesis of Inorganic Nanomaterials; Mohan Bhagyaraj, S., Oluwafemi, O.S., Kalarikkal, N., Thomas, S., Eds.; Woodhead Publishing: Sawston, UK, 2018; pp. 169–184. [Google Scholar] [CrossRef]
- Noah, N. Chapter 6—Green synthesis: Characterization and application of silver and gold nanoparticles. In Green Synthesis, Characterization and Applications of Nanoparticles; Shukla, A.K., Iravani, S., Eds.; Elsevier: Amsterdam, The Netherlands, 2019; pp. 111–135. [Google Scholar] [CrossRef]
- Ghosh, S. Chapter 4—Green synthesis of nanoparticles and fungal infection. In Green Synthesis, Characterization and Applications of Nanoparticles; Shukla, A.K., Iravani, S., Eds.; Elsevier: Amsterdam, The Netherlands, 2019; pp. 75–86. [Google Scholar] [CrossRef]
- Aderibigbe, B.A. Metal-Based Nanoparticles for the Treatment of Infectious Diseases. Molecules 2017, 22, 1370. [Google Scholar] [CrossRef]
- Gao, W.; Thamphiwatana, S.; Angsantikul, P.; Zhang, L. Nanoparticle approaches against bacterial infections. Wiley Interdiscip. Rev. Nanomed. Nanobiotechnol. 2014, 6, 532–547. [Google Scholar] [CrossRef] [PubMed]
- Mba, I.E.; Nweze, E.I. Nanoparticles as therapeutic options for treating multidrug-resistant bacteria: Research progress, challenges, and prospects. World J. Microbiol. Biotechnol. 2021, 37, 108. [Google Scholar] [CrossRef] [PubMed]
- Pan, S.; Goudoulas, T.B.; Jeevanandam, J.; Tan, K.X.; Chowdhury, S.; Danquah, M.K. Therapeutic Applications of Metal and Metal-Oxide Nanoparticles: Dermato-Cosmetic Perspectives. Front. Bioeng. Biotechnol. 2021, 9, 710. [Google Scholar] [CrossRef] [PubMed]
- Lakshmipriya, T.; Gopinath, S.C.B. Introduction to nanoparticles and analytical devices. In Nanoparticles in Analytical and Medical Devices; Gopinath, S.C.B., Gang, F., Eds.; Elsevier: Amsterdam, The Netherlands, 2021; pp. 1–29. [Google Scholar] [CrossRef]
- Santos, S.N.D.; Bernardes, E.S.; Santos-Oliveira, R. Chapter 18—Nanoradiopharmaceuticals in current molecular medicine. In Fundamentals of Nanoparticles; Barhoum, A., Hamdy Makhlouf, A.S., Eds.; Elsevier: Amsterdam, The Netherlands, 2018; pp. 553–569. [Google Scholar] [CrossRef]
- Mokammel, M.A.; Islam, M.J.; Hasanuzzaman, M.; Hashmi, S. Nanoscale Materials for Self-Cleaning and Antibacterial Applications. In Reference Module in Materials Science and Materials Engineering; Elsevier: Amsterdam, The Netherlands, 2019. [Google Scholar] [CrossRef]
- Casero, C.; Machín, F.; Méndez-Álvarez, S.; Demo, M.; Ravelo, Á.G.; Pérez-Hernández, N.; Joseph-Nathan, P.; Estévez-Braun, A. Structure and antimicrobial activity of phloroglucinol derivatives from Achyrocline satureioides. J. Nat. Prod. 2015, 78, 93–102. [Google Scholar] [CrossRef] [PubMed]
- Rocha, L.; Marston, A.; Potterat, O.; Kaplan, M.A.; Stoeckli-Evans, H.; Hostettmann, K. Antibacterial phloroglucinols and flavonoids from Hypericum brasiliense. Phytochemistry 1995, 40, 1447–1452. [Google Scholar] [CrossRef]
- Gupta, P.; Kumar, R.; Garg, P.; Singh, I.P. Active site binding modes of dimeric phloroglucinols for HIV-1 reverse transcriptase, protease and integrase. Bioorg. Med. Chem. Lett. 2010, 20, 4427–4431. [Google Scholar] [CrossRef] [PubMed]
- Drygalski, K.; Siewko, K.; Chomentowski, A.; Odrzygóźdź, C.; Zalewska, A.; Krętowski, A.; Maciejczyk, M. Phloroglucinol Strengthens the Antioxidant Barrier and Reduces Oxidative/Nitrosative Stress in Nonalcoholic Fatty Liver Disease (NAFLD). Oxid. Med. Cell. Longev. 2021, 2021, 8872702. [Google Scholar] [CrossRef]
- Adamu, M.; Mukandiwa, L.; Awouafack, M.D.; Ahmed, A.S.; Eloff, J.N.; Naidoo, V. Ultrastructure changes induced by the phloroglucinol derivative agrimol G isolated from Leucosidea sericea in Haemonchus contortus. Exp. Parasitol. 2019, 207, 107780. [Google Scholar] [CrossRef]
- Erpel, F.; Mateos, R.; Pérez-Jiménez, J.; Pérez-Correa, J.R. Phlorotannins: From isolation and structural characterization, to the evaluation of their antidiabetic and anticancer potential. Food Res. Int. 2020, 137, 109589. [Google Scholar] [CrossRef]
- Lee, N.-Y.; Ko, W.-C.; Hsueh, P.-R. Nanoparticles in the Treatment of Infections Caused by Multidrug-Resistant Organisms. Front. Pharmacol. 2019, 10, 1153. [Google Scholar] [CrossRef] [Green Version]
- McNeil, S.E. Nanoparticle therapeutics: A personal perspective. WIREs Nanomed. Nanobiotechnol. 2009, 1, 264–271. [Google Scholar] [CrossRef]
- McNeil, S.E. Unique benefits of nanotechnology to drug delivery and diagnostics. Methods Mol. Biol. 2011, 697, 3–8. [Google Scholar] [CrossRef] [PubMed]
- Singh, J.; Dutta, T.; Kim, K.-H.; Rawat, M.; Samddar, P.; Kumar, P. ‘Green’ synthesis of metals and their oxide nanoparticles: Applications for environmental remediation. J. Nanobiotechnol. 2018, 16, 84. [Google Scholar] [CrossRef]
- Altemimi, A.; Lakhssassi, N.; Baharlouei, A.; Watson, D.G.; Lightfoot, D.A. Phytochemicals: Extraction, Isolation, and Identification of Bioactive Compounds from Plant Extracts. Plants 2017, 6, 42. [Google Scholar] [CrossRef]
- Khan, F.; Park, S.-K.; Bamunuarachchi, N.I.; Oh, D.; Kim, Y.-M. Caffeine-loaded gold nanoparticles: Antibiofilm and anti-persister activities against pathogenic bacteria. Appl. Microbiol. Biotechnol. 2021, 105, 3717–3731. [Google Scholar] [CrossRef]
- Kumar, P.; Senthamilselvi, S.; Govindaraju, M. Phloroglucinol-encapsulated starch biopolymer: Preparation, antioxidant and cytotoxic effects on HepG2 liver cancer cell lines. RSC Adv. 2014, 4, 26787–26795. [Google Scholar] [CrossRef]
- Khan, F.; Manivasagan, P.; Lee, J.W.; Pham, D.T.N.; Oh, J.; Kim, Y.M. Fucoidan-Stabilized Gold Nanoparticle-Mediated Biofilm Inhibition, Attenuation of Virulence and Motility Properties in Pseudomonas aeruginosa PAO1. Mar. Drugs 2019, 17, 208. [Google Scholar] [CrossRef] [Green Version]
- Chaudhary, A.; Kumar, N.; Kumar, R.; Salar, R.K. Antimicrobial activity of zinc oxide nanoparticles synthesized from Aloe vera peel extract. SN Appl. Sci. 2018, 1, 136. [Google Scholar] [CrossRef] [Green Version]
- Jain, D.; Shivani; Bhojiya, A.A.; Singh, H.; Daima, H.K.; Singh, M.; Mohanty, S.R.; Stephen, B.J.; Singh, A. Microbial Fabrication of Zinc Oxide Nanoparticles and Evaluation of Their Antimicrobial and Photocatalytic Properties. Front. Chem. 2020, 8, 778. [Google Scholar] [CrossRef] [PubMed]
- Elbagory, A.M.; Cupido, C.N.; Meyer, M.; Hussein, A.A. Large Scale Screening of Southern African Plant Extracts for the Green Synthesis of Gold Nanoparticles Using Microtitre-Plate Method. Molecules 2016, 21, 1498. [Google Scholar] [CrossRef] [Green Version]
- Khatami, M.; Alijani, H.Q.; Heli, H.; Sharifi, I. Rectangular shaped zinc oxide nanoparticles: Green synthesis by Stevia and its biomedical efficiency. Ceram. Int. 2018, 44, 15596–15602. [Google Scholar] [CrossRef]
- Taylor, P.K.; Yeung, A.T.; Hancock, R.E. Antibiotic resistance in Pseudomonas aeruginosa biofilms: Towards the development of novel anti-biofilm therapies. J. Biotechnol. 2014, 191, 121–130. [Google Scholar] [CrossRef] [PubMed]
- Lee, J.-H.; Kim, Y.-G.; Cho, M.H.; Lee, J. ZnO nanoparticles inhibit Pseudomonas aeruginosa biofilm formation and virulence factor production. Microbiol. Res. 2014, 169, 888–896. [Google Scholar] [CrossRef]
- Khan, F.; Lee, J.W.; Manivasagan, P.; Pham, D.T.N.; Oh, J.; Kim, Y.M. Synthesis and characterization of chitosan oligosaccharide-capped gold nanoparticles as an effective antibiofilm drug against the Pseudomonas aeruginosa PAO1. Microb. Pathog. 2019, 135, 103623. [Google Scholar] [CrossRef]
- Chua, S.L.; Liu, Y.; Yam, J.K.H.; Chen, Y.; Vejborg, R.M.; Tan, B.G.C.; Kjelleberg, S.; Tolker-Nielsen, T.; Givskov, M.; Yang, L. Dispersed cells represent a distinct stage in the transition from bacterial biofilm to planktonic lifestyles. Nat. Commun. 2014, 5, 4462. [Google Scholar] [CrossRef] [PubMed]
- Maslova, E.; Eisaiankhongi, L.; Sjöberg, F.; McCarthy, R.R. Burns and biofilms: Priority pathogens and in vivo models. NPJ Biofilms Microbiomes 2021, 7, 73. [Google Scholar] [CrossRef]
- Verderosa, A.D.; Totsika, M.; Fairfull-Smith, K.E. Bacterial Biofilm Eradication Agents: A Current Review. Front. Chem. 2019, 7, 824. [Google Scholar] [CrossRef] [Green Version]
- Perveen, K.; Husain, F.M.; Qais, F.A.; Khan, A.; Razak, S.; Afsar, T.; Alam, P.; Almajwal, A.M.; Abulmeaty, M.M.A. Microwave-Assisted Rapid Green Synthesis of Gold Nanoparticles Using Seed Extract of Trachyspermum ammi: ROS Mediated Biofilm Inhibition and Anticancer Activity. Biomolecules 2021, 11, 197. [Google Scholar] [CrossRef]
- Kaur, T.; Putatunda, C.; Vyas, A.; Kumar, G. Zinc oxide nanoparticles inhibit bacterial biofilm formation via altering cell membrane permeability. Prep. Biochem. Biotechnol. 2021, 51, 309–319. [Google Scholar] [CrossRef]
- Dwivedi, S.; Wahab, R.; Khan, F.; Mishra, Y.K.; Musarrat, J.; Al-Khedhairy, A.A. Reactive Oxygen Species Mediated Bacterial Biofilm Inhibition via Zinc Oxide Nanoparticles and Their Statistical Determination. PLoS ONE 2014, 9, e111289. [Google Scholar] [CrossRef]
- Grainha, T.; Jorge, P.; Alves, D.; Lopes, S.P.; Pereira, M.O. Unraveling Pseudomonas aeruginosa and Candida albicans Communication in Coinfection Scenarios: Insights Through Network Analysis. Front. Cell. Infect. Microbiol. 2020, 10, 550505. [Google Scholar] [CrossRef] [PubMed]
- Khan, F.; Lee, J.W.; Pham, D.T.N.; Lee, J.H.; Kim, H.W.; Kim, Y.K.; Kim, Y.M. Streptomycin mediated biofilm inhibition and suppression of virulence properties in Pseudomonas aeruginosa PAO1. Appl. Microbiol. Biotechnol. 2020, 104, 799–816. [Google Scholar] [CrossRef] [PubMed]
- Cegelski, L.; Marshall, G.R.; Eldridge, G.R.; Hultgren, S.J. The biology and future prospects of antivirulence therapies. Nat. Rev. Microbiol. 2008, 6, 17–27. [Google Scholar] [CrossRef] [PubMed]
- Clatworthy, A.E.; Pierson, E.; Hung, D.T. Targeting virulence: A new paradigm for antimicrobial therapy. Nat. Chem. Biol. 2007, 3, 541–548. [Google Scholar] [CrossRef]
- Ishida, T.; Ikeda, T.; Takiguchi, N.; Kuroda, A.; Ohtake, H.; Kato, J. Inhibition of quorum sensing in Pseudomonas aeruginosa by N-acyl cyclopentylamides. Appl. Environ. Microbiol. 2007, 73, 3183–3188. [Google Scholar] [CrossRef] [Green Version]
- Qais, F.A.; Ahmad, I.; Altaf, M.; Alotaibi, S.H. Biofabrication of Gold Nanoparticles Using Capsicum annuum Extract and Its Antiquorum Sensing and Antibiofilm Activity against Bacterial Pathogens. ACS Omega 2021, 6, 16670–16682. [Google Scholar] [CrossRef]
- Ali, S.G.; Ansari, M.A.; Alzohairy, M.A.; Alomary, M.N.; Jalal, M.; AlYahya, S.; Asiri, S.M.M.; Khan, H.M. Effect of Biosynthesized ZnO Nanoparticles on Multi-Drug Resistant Pseudomonas aeruginosa. Antibiotics 2020, 9, 260. [Google Scholar] [CrossRef]
- Pourhajibagher, M.; Bahador, A. Enhanced reduction of polymicrobial biofilms on the orthodontic brackets and enamel surface remineralization using zeolite-zinc oxide nanoparticles-based antimicrobial photodynamic therapy. BMC Microbiol. 2021, 21, 273. [Google Scholar] [CrossRef]
- Rónavári, A.; Igaz, N.; Gopisetty, M.K.; Szerencsés, B.; Kovács, D.; Papp, C.; Vágvölgyi, C.; Boros, I.M.; Kónya, Z.; Kiricsi, M.; et al. Biosynthesized silver and gold nanoparticles are potent antimycotics against opportunistic pathogenic yeasts and dermatophytes. Int. J. Nanomed. 2018, 13, 695–703. [Google Scholar] [CrossRef] [Green Version]
- Pekmezovic, M.; Aleksic, I.; Barac, A.; Arsic-Arsenijevic, V.; Vasiljevic, B.; Nikodinovic-Runic, J.; Senerovic, L. Prevention of polymicrobial biofilms composed of Pseudomonas aeruginosa and pathogenic fungi by essential oils from selected Citrus species. Pathog. Dis. 2016, 74, ftw102. [Google Scholar] [CrossRef] [Green Version]
- Fazlurrahman; Batra, M.; Suri, C.R.; Jain, R.K.; Senerovic, L. Isolation and characterization of an atrazine-degrading Rhodococcus sp. strain MB-P1 from contaminated soil. Lett. Appl. Microbiol. 2009, 49, 721–729. [Google Scholar] [CrossRef] [PubMed]
- Ebadi, M.; Zolfaghari, M.R.; Aghaei, S.S.; Zargar, M.; Shafiei, M.; Zahiri, H.S.; Noghabi, K.A. A bio-inspired strategy for the synthesis of zinc oxide nanoparticles (ZnO NPs) using the cell extract of cyanobacterium Nostoc sp. EA03: From biological function to toxicity evaluation. RSC Adv. 2019, 9, 23508–23525. [Google Scholar] [CrossRef] [Green Version]
- Essar, D.W.; Eberly, L.; Hadero, A.; Crawford, I.P. Identification and characterization of genes for a second anthranilate synthase in Pseudomonas aeruginosa: Interchangeability of the two anthranilate synthases and evolutionary implications. J. Bacteriol. 1990, 172, 884–900. [Google Scholar] [CrossRef] [Green Version]
- Chandika, P.; Kim, M.S.; Khan, F.; Kim, Y.M.; Heo, S.Y.; Oh, G.W.; Kim, N.G.; Jung, W.K. Wound healing properties of triple cross-linked poly (vinyl alcohol)/methacrylate kappa-carrageenan/chitooligosaccharide hydrogel. Carbohydr. Polym. 2021, 269, 118272. [Google Scholar] [CrossRef] [PubMed]

Publisher’s Note: MDPI stays neutral with regard to jurisdictional claims in published maps and institutional affiliations. |
© 2021 by the authors. Licensee MDPI, Basel, Switzerland. This article is an open access article distributed under the terms and conditions of the Creative Commons Attribution (CC BY) license (https://creativecommons.org/licenses/by/4.0/).
Share and Cite
Khan, F.; Kang, M.-G.; Jo, D.-M.; Chandika, P.; Jung, W.-K.; Kang, H.W.; Kim, Y.-M. Phloroglucinol-Gold and -Zinc Oxide Nanoparticles: Antibiofilm and Antivirulence Activities towards Pseudomonas aeruginosa PAO1. Mar. Drugs 2021, 19, 601. https://doi.org/10.3390/md19110601
Khan F, Kang M-G, Jo D-M, Chandika P, Jung W-K, Kang HW, Kim Y-M. Phloroglucinol-Gold and -Zinc Oxide Nanoparticles: Antibiofilm and Antivirulence Activities towards Pseudomonas aeruginosa PAO1. Marine Drugs. 2021; 19(11):601. https://doi.org/10.3390/md19110601
Chicago/Turabian StyleKhan, Fazlurrahman, Min-Gyun Kang, Du-Min Jo, Pathum Chandika, Won-Kyo Jung, Hyun Wook Kang, and Young-Mog Kim. 2021. "Phloroglucinol-Gold and -Zinc Oxide Nanoparticles: Antibiofilm and Antivirulence Activities towards Pseudomonas aeruginosa PAO1" Marine Drugs 19, no. 11: 601. https://doi.org/10.3390/md19110601
APA StyleKhan, F., Kang, M.-G., Jo, D.-M., Chandika, P., Jung, W.-K., Kang, H. W., & Kim, Y.-M. (2021). Phloroglucinol-Gold and -Zinc Oxide Nanoparticles: Antibiofilm and Antivirulence Activities towards Pseudomonas aeruginosa PAO1. Marine Drugs, 19(11), 601. https://doi.org/10.3390/md19110601

